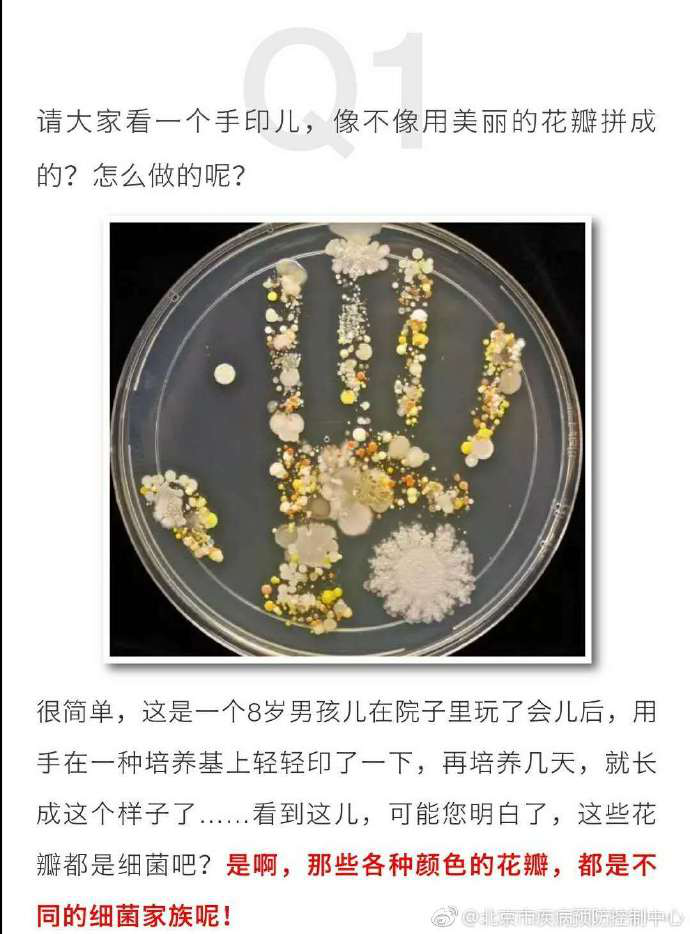
图片2.png

春季是传染性疾病多发季节,常见传染病包括:流行性感冒、水痘、结核病、麻疹、风疹、流行性腮腺炎、流行性脑脊髓膜炎、诺如病毒急性胃肠炎等。这些传染病大多是呼吸道传染病,通过呼吸、近距离飞沫或接触呼吸道分泌物等途径传播。学校是集体生活环境,人员比较密集、流动性大的地方,一旦出现传染病疫情比较容易传播,给广大师生的工作学习带来较大的影响,因此我们给大家介绍一下春季常见传染病的预防知识。
一、春季常见传染病:
1.流行性感冒简称流感,是由流感病毒引起的急性呼吸道传染病,传染性极高, 传染源是流感患者。流感主要在人多拥挤的密闭环境中经空气或飞沫传播,亦可通过直接接触患者的分泌物而传播。 人群普遍易感。潜伏期短,通常为l-3日。主要症状为:发热、头痛、咽痛、咳嗽,全身肌肉、关节疼痛,还可出现肠胃不适等。发病期间需要隔离,体温恢复正常、流感样症状消失后48小时后可复课。
2.水痘,是由水痘带状疱疹病毒(疱疹病毒的一种)引起的一种急性呼吸道传染病。 传染源是水痘患者。水痘通过患者咳嗽产生的飞沫或散布在空气中的鼻咽喉分泌物传播,也可经人与人接触直接传播。 人群普遍易感,潜伏期为21天,病愈后可获终身免疫。主要症状为发热、头痛及上呼吸道感染症状,持续1天左右,起病后数小时或1-2日出现皮疹,皮疹首见于头部和躯干,以斑疹、丘疹及迅速发展的疱疹和结痂为其特征。发病期间需要隔离,自发病至水痘疱疹全部结痂,痂皮全部脱落后可复课。
3.结核病,是结核杆菌引起的呼吸道传染病。结核菌可侵犯人体各个脏器,以肺部侵犯最为常见,多数病人表现为逐渐起病,主要症状为持续低热,尤以午后低热多见,同时有咳嗽、咳痰、盗汗、疲乏、纳差、消瘦、胸痛、咯血等。如果咳嗽、咳痰超过两周以上就要及时前往医院就诊。结核病传染性强,疗程长,一般需要一年,一旦确诊需要休学治疗。
4.麻疹,是由麻疹病毒引起的急性呼吸道传染病。 传染源是麻疹患者。麻疹主要是通过飞沫或直接接触患者的鼻咽喉分泌物传播。 人群普遍易感。麻疹的潜伏期为7-1 8日,通常为1 4日。病愈后有持久免疫力。 麻疹发病季节以冬春季为多,但全年均可发生。 其主要症状为:发热、咳嗽、口腔粘膜斑等症状,发热三四天后会出现红色斑丘状皮疹,从耳后、头面部,向全身扩散。持续5-6天后逐渐消退,皮肤上会有脱屑,也会有色素沉着,7-10天后痊愈。发病期需要隔离,隔离至出疹后4天,并发肺部感染着延长至14天。
5.风疹,是由风疹病毒通过呼吸道和直接接触传播引起的急性呼吸道传染病。传染源是风疹患者。风疹主要通过呼吸道飞沫传播,也可通过口、鼻及眼睛分泌物直接接触传播。主要症状:全身散在红色斑丘疹及耳后、枕部淋巴结肿大为特征。发病期需要隔离,隔离至出疹后4天,并发肺部感染着延长至10天。
6.流行性腮腺炎,是由腮腺炎病毒所引起的急性呼吸道传染病。 传染源是腮腺炎患者和携带病毒者。流行性腮腺炎可经直接接触患者的唾液或飞沫传播。潜伏期为1 2-25日,通常为1 8日。感染后一般可获得持久免疫力。流行性腮腺炎全年均有发病,但以冬春季为主。 主要症状:前期症状可出现发热、头痛、无力、食欲不振等,发病1-2日后出现唾液腺肿大,通常可见一侧或双侧腮腺肿大,除腮腺肿胀外,还可引起脑膜炎、脑膜脑炎、睾丸炎、卵巢炎、胰腺炎等。发病期需要隔离,隔离至发病后21天。
7.流行性脑脊髓膜炎简称流脑,由脑膜炎双球菌引起急性呼吸道传染病,传染性较强。传染源是流脑患者或带菌者。主要症状:突发高热、剧烈头痛、频繁呕吐、皮肤粘膜淤点和脑膜刺激征,严重者可有败血症休克及脑实质损害,脑脊液呈化脓性改变。发病期需要隔离,隔离至症状消失后7天。
8.诺如病毒胃肠炎,是由诺如病毒感染引起,是春季学校高发的传染病。由于呕吐是诺如病毒胃肠炎最常见症状,所以该病又被称为“冬季呕吐病”。诺如病毒感染的潜伏期通常为24-48小时,最短12小时,最长72小时。主要症状是呕吐和腹泻,其次为恶心、腹痛、头痛、发热、畏寒和肌肉酸痛等。成人和儿童诺如病毒急性胃肠炎症状有所区别,儿童以呕吐为主,成人则腹泻居多。诺如病毒传染性很强,诺如病毒胃肠炎患者的粪便和呕吐物中含有大量的病毒,处置不当很容易造成感染,主要通过粪-口途径传播,包括摄入患者粪便或呕吐物产生的气溶胶,或者摄入粪便或呕吐物污染的食物或水,以及间接接触被粪便或呕吐物污染的环境物体表面都可能感染诺如病毒。发病期需要隔离,隔离至症状消失后72小时。
二、预防传染病的一般措施:
传染病流行的时候,切断传染病流行的三个基本环节(传染源、传播途径、易感人群)中的任何一个环节,传染病的流行即可终止。针对传染病流行的三个基本环节,预防传染病的措施可分为以下三方面:
1、控制传染源
传染病在发病前就已经具备了传染性,当发病初期表现出传染病症状的时候,传染性最强。因此,对传染病人要尽可能早发现、早诊断、早报告、早治疗、早隔离,防止传染病蔓延。
2、切断传播途径
切断传播途径的方法,主要是讲究个人卫生和环境卫生。消灭传播疾病的媒介生物,进行一些必要的消毒工作,使病原体丧失感染健康人体的机会。
3、保护易感人群
在传染病流行期间注意保护易感者,避免与传染源接触,进行预防接种,提高易感人群抵抗力。对易感者本人来说,应该积极锻炼身体,增强免疫力。开展爱国卫生运动,搞好环境和个人卫生,消灭苍蝇、蚊子、老鼠、蟑螂等。
三、学校春季传染病预防措施:
1、合理膳食、增加营养、多饮水、摄入足够维生素及微量元素,宜多食富含蛋白质及微量元素食物,如:瘦肉、禽蛋、大枣、蜂蜜和新鲜蔬菜、水果等,积极参加体育锻炼,多到户外呼吸新鲜空气,每日散步、慢跑、做操、太极拳等增强体质。
2、传染病流行期间,不参加或尽量减少学校聚会,不到人员密集、人员混杂、空气污染的场所去,如:农贸市场、个体饮食店、游艺活动室等。
3、提供合理的洗手设施,勤洗手,使用肥皂或洗手液并用流动水洗手,不用污染的毛巾擦手。双手接触呼吸道分泌物后(如打喷嚏后)应立即洗手。
4、每天开窗通风,保持教室、寝室内空气新鲜。
5、合理安排作息时间,生活规律,避免劳累,预防感冒。
6、不食、不加工不清洁的食物,不生食各种海产品和肉类,不喝生水。不随意丢弃垃圾,垃圾分类并统一销毁。
7、注意个人卫生,不随意吐痰、打喷嚏,学会咳嗽礼仪。
8、发热或身体不适时及时就医,回宿舍后洗手,避免交叉感染。
9、避免接触传染病病人,尽量不要前往传染病流行疫区。
10、传染病病人用过的物品及房间适当消毒,如日光下晾晒衣被、室内桌面、地面、水龙头及门把手等用含氯消毒剂喷洒、擦拭。
春季传染病虽然种类繁多,但只要我们重视预防,做到早发现、早诊断、早报告、早治疗、早隔离,就可以有效阻传染病在校内的流行与传播。
北京语言大学校医院
保健科
2019年3月15日